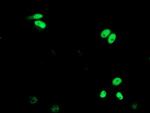
XPF Antibody in Immunocytochemistry (ICC/IF)

Search
OriGene
XPF Monoclonal Antibody (OTI6E6), TrueMAB™
{{$productOrderCtrl.translations['antibody.pdp.commerceCard.promotion.promotions']}}
{{$productOrderCtrl.translations['antibody.pdp.commerceCard.promotion.viewpromo']}}
{{$productOrderCtrl.translations['antibody.pdp.commerceCard.promotion.promocode']}}: {{promo.promoCode}} {{promo.promoTitle}} {{promo.promoDescription}}. {{$productOrderCtrl.translations['antibody.pdp.commerceCard.promotion.learnmore']}}
产品信息
CF503294
宿主/亚型
分类
类型
克隆号
抗原
偶联物
形式
浓度
规格
保存条件
运输条件
产品详细信息
For reconstitution, we recommend adding 100 µL distilled water to a final antibody concentration of about 1 mg/mL. To use this carrier-free antibody for conjugation experiments, we strongly recommend performing another round of desalting. (Zeba Spin Desalting Columns, 7KMWCO, 0.5 mL, Product # 89882)
靶标信息
The structure specific ERCC 1 / XPF endonuclease complex is implicated in the repair of two distinct types of lesions in DNA: NER for UV induced lesions and bulky chemical adducts; and recombination repair of the very genotoxic interstrand cross links. NER mechanism involves dual incisions on both sides of the damage catalyzed by two nucleases. In mammalian cells, XPG cleaves 3' of the DNA lesion while the ERCC1 / XPF complex makes the 5' incision. ERCC1 / XPF probably plays a role in processing partially processed recombination intermediates.
仅用于科研。不用于诊断过程。未经明确授权不得转售。